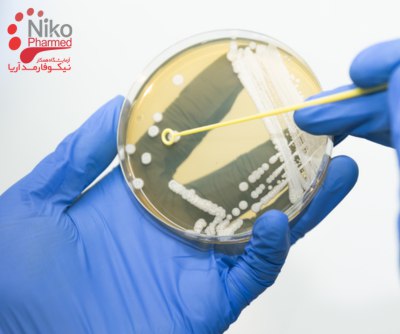
روش های تست استریلیتی روش های تست استریلیتی

آزمون استریلیتی چیست؟
آزمون استریلیتی برای تعیین این که آیا محصول حاوی میکروارگانیسمهای زنده مانند باکتریها، قارچها و ویروسها است یا خیر، انجام میشود.
این آزمون در صنایع داروسازی، تجهیزات پزشکی، بیوتکنولوژی و تولید مواد غذایی برای اطمینان از ایمنی و کارایی محصولات که قرار است استریل باشند، ضروری است.
این تست بر روی محصول نهایی کارخانه های تولید مواد دارویی و تجهیزات پزشکی انجام می شود و یکی از تست های کنترل کیفی است که برای این نمونه ها مشخص شده است.
به طور خلاصه ، استریلیتی را می توان به عنوان عدم وجود میکروارگانیسم های زنده تعریف کرد. با این حال، شرایطی که استریلیتی مطلق را تضمین می کند معمولاً برای مواد فعال بسیار سخت است و تعریف استریل برای یک فرآورده دارویی باید از نظر عملکردی تعریف شود.

برای کسب اطلاعات بیشتر و دریافت خدمات با ما تماس بگیرید.
روش های تست استریلیتی
- تلقیح مستقیم
در این روش، نمونه آزمایشی مستقیماً به دو نوع محیط تلقیح می شود تا امکان تشخیص میکروارگانیسم های هوازی و بی هوازی را فراهم کند. آزمایش استریلیتی به روش مستقیم، روشی انتخابی برای تجهیزات پزشکی است. پس از تلقیح، هر دو نوع محیط به مدت 14 روز انکوبه می شوند. مشاهدات متناوب روزانه و همچنین مشاهده نهایی در پایان دوره آزمایش برای شناسایی شواهد آلودگی میکروبی انجام می شود.
- فیلتراسیون غشایی
روش فیلتراسیون غشایی برای تست استریلیتی محصولات دارویی مورد استفاده قرار می گیرد. تست استریلیتی فیلتراسیون غشایی برای تجهیزات پزشکی که حاوی مواد نگهدارنده هستند نیز ترجیح داده می شود.
در این آزمون، نمونه ها با استفاده از فلوییدهای مختلف شستشو داده و از طریق فیلتراسیون از میان فیلتر غشایی عبور داده می شوند و نهایتا فیلترها در دو نوع محیط به مدت 14 روز انکوبه می شوند و تشخیص میکروارگانیسم های هوازی و بی هوازی را امکانپذیر می سازد.
محیط های کشت مورد استفاده در تست استریلیتی عبارتند از تیوگلیکولات مایع (FTM) و محیط هضم سویا-کازئین (TSB).
برای انجام آزمون استریلیتی، کنترل کیفی محیط های کشت مورد استفاده الزامی است. آزمون تحریک رشد (Growth promotion test) جهت کنترل کیفی محیط های کشت مورد استفاده در آزمون استریلیتی به کار می رود.
در زمان انجام هر آزمون استریلیتی، حتما کنترل منفی و کنترل مثبت برای هر یک از محیط های کشت انجام می شود تا نتایج نهایی قابل استناد باشند.
- Stasis test
آزمونStasis ، آزمون اجباری نیست، اما توصیه می شود که آزمایشStasis در زمانی انجام شود که آنتی بیوتیک ها، محصولات ضد میکروبی یا نگهدارنده ها آزمایش می شوند. در این آزمایش 10-100 CFU از میکروارگانیسم های به طور مستقیم به ظروف آزمایش حاوی محصول، اضافه می شود که در پایان دوره انکوباسیون 14 روزه هیچ گونه نشانه ای از آلودگی نشان ندهد. میکروارگانیسم های آزمونStasis باید رشد واضحی را در مدت 3 روز برای باکتری ها و 5 روز برای قارچ ها نشان دهند ، در غیر این صورت آزمایش نامعتبر است.
توصیه می شود که آزمون Stasis برای هر گروه از محصولات مربوطه یا زمانی که محصول مجدداً فرموله شده یا محیط های کشت تغییر داده شدند، حداقل هر 12 ماه یکبار تکرار شود و سوابق تست Stasis نگهداری شود.
مراحل آزمون استریلیتی
-
آمادهسازی نمونه:
- نمونهها تحت شرایط آسپتیک گرفته میشوند تا از آلودگی جلوگیری شود. این ممکن است شامل ضدعفونی و دستکاری دقیق باشد تا اطمینان حاصل شود که هر میکروارگانیسمی که تشخیص داده میشود، واقعاً از نمونه است.
-
تلقیح:
- نمونه در محیط کشت مناسب معرفی میشود. این ممکن است شامل تلقیح مستقیم یا فیلتراسیون غشایی بسته به روش انتخاب شده باشد.
-
انکوباسیون:
- محیطهای تلقیح شده تحت شرایط مشخص (دما، زمان و محیط) انکوبه میشوند که رشد پتانسیل آلودگی را تسهیل میکند. معمولاً انکوباسیون به مدت 14 روز طول میکشد.
-
مشاهده و تجزیه و تحلیل:
- پس از دوره انکوباسیون، محیطها برای علائم رشد میکروبی بازرسی میشوند. عدم وجود رشد نشاندهنده استریل بودن محصول است.
اهمیت انجام تست استریلیتی در صنعت تجهیزات پزشکی
آزمون استریلیتی در صنعت تجهیزات پزشکی از اهمیت حیاتی برخوردار است زیرا این تجهیزات بهطور مستقیم با بدن بیماران در تماس هستند و هرگونه آلودگی میکروبی میتواند به عواقب جدی برای سلامتی آنها منجر شود. دلایل اصلی اهمیت انجام این تست در صنعت تجهیزات پزشکی عبارتند از:
ایمنی در جراحیها و رویههای پزشکی و جلوگیری از عفونتهای بیمارستانی:
تجهیزات پزشکی مانند سرنگها، کاتترها، ایمپلنتها و ابزار جراحی بهطور مستقیم با بدن بیماران در تماس هستند. وجود هرگونه میکروارگانیسم بر روی این تجهیزات میتواند منجر به عفونتهای جدی و حتی تهدیدکننده زندگی شود.
عفونتهای بیمارستانی یکی از مشکلات جدی در مراکز درمانی است که میتواند منجر به افزایش مرگومیر و هزینههای درمانی شود. اطمینان از استریل بودن تجهیزات پزشکی به کاهش خطر این نوع عفونتها کمک میکند.
رعایت استانداردها و مقررات:
سازمانهای بهداشتی و مقررات بینالمللی مانند FDA (سازمان غذا و داروی آمریکا)، ISO (سازمان بینالمللی استاندارد) و CE (نشان اروپایی) استانداردهای سختگیرانهای برای تجهیزات پزشکی تعیین کردهاند. انجام آزمونهای استریلیتی بهمنظور رعایت این استانداردها ضروری است و به تولیدکنندگان اجازه میدهد تا محصولات خود را به بازارهای جهانی عرضه کنند.
تضمین کیفیت و ایمنی محصولات:
- انجام آزمونهای استریلیتی به تولیدکنندگان کمک میکند تا از کیفیت و ایمنی تجهیزات پزشکی خود اطمینان حاصل کنند. این کار باعث افزایش اعتماد پزشکان و بیماران به محصولات آنها میشود.
کنترل کیفیت و کاهش هزینهها:
با انجام آزمونهای استریلیتی منظم، تولیدکنندگان میتوانند هرگونه مشکل در فرآیند استریلیزاسیون را شناسایی و برطرف کنند. این کار به بهبود فرآیندها و کاهش هزینههای مرتبط با تولید و همچنین جلوگیری از فراخوانی محصولات کمک میکند.
آزمون استریلیتی در صنعت تجهیزات پزشکی بهعنوان یکی از مراحل حیاتی تضمین کیفیت و ایمنی محصولات شناخته میشود. این آزمونها با رعایت استانداردهای بینالمللی و مقررات بهداشتی، نهتنها سلامت بیماران را تضمین میکنند بلکه به تولیدکنندگان کمک میکنند تا محصولات با کیفیت و مطمئنی را به بازار عرضه کنند. بهاینترتیب، انجام منظم و دقیق این آزمونها برای حفظ و ارتقاء سطح بهداشت و ایمنی در صنعت تجهیزات پزشکی ضروری است.
نیکوفارمد یکی از معتبرترین آزمایشگاههای تخصصی در زمینه انجام تستهای استریلیتی برای تجهیزات پزشکی و محصولات دارویی است. با بهرهگیری از تکنولوژیهای پیشرفته و تیمی از متخصصان مجرب، نیکوفارمد توانسته است جایگاه برجستهای در صنعت آزمایشگاهی کسب کند.
استریلیتی در ظروف دارویی
در مواد دارویی، ظرف زمانی به عنوان استریل تعریف می شود که احتمال آلودگی آن به میکروارگانیسم های در حال تکثیر کمتر از یک از یک میلیون باشد. از آنجایی که امکان باز کردن و آزمایش هر ظروف یک فرآورده دارویی بیولوژیکی وجود ندارد، باید از تعدادی نمونه که معرف مقدار مورد آزمایش و در زمانهای مختلف در طول عملیات بسته بندی است، برای نظارت بر استریل استفاده شود. این بدان معناست که وقتی فقط چند ظرف غیر استریل در یک مجموعه بسیار بزرگ از ظروف همگن وجود داشته باشد، احتمال تشخیص یک ظرف غیر استریل نسبتاً کم است. به همین دلیل آزمایش استریلیتی از روشهایی با حساسیت گسترده استفاده میکند، معمولاً انکوباسیون نمونهها در محیطهای رشد باعث رشد در طیف وسیعی از میکروارگانیسمها میشود، جایی که تکثیر را میتوان به صورت بصری تشخیص داد.
کاربرد فناوری اتاق تمیز در استریلیتی
استریلیتی همچنین از روش هایی مانند فناوری اتاق تمیز استفاده می کند که به طور موثر از آلودگی مواد بیولوژیکی جلوگیری میکند. آزمایشهای آلایندههای ویروسی، که معمولاً در الزامات محصول مشخص میشوند، پیچیدهتر و پرهزینهتر هستند. دستورالعملهای آزمایش استریلیتی سازمان جهانی بهداشت در طیف گستردهای از محصولات دارویی بیولوژیکی از جمله واکسنها، فرآوردههای خونی، محصولات بیوتکنولوژی و محصولات سلولی و بافتی قابل اعمال است.
در سال های اخیر، پیشرفت هایی در روش های مولکولی مانند تکنیک های تقویت اسید نوکلئیک (NAT) صورت گرفته است. اگرچه آزمایشهای عمومی گسترده برای شناسایی آلایندههای ناشناخته ترجیح داده میشوند، برخی از ویروسهای انتخاب شده ممکن است با استفاده از سنجش NAT غربالگری شوند. علاوه بر این، این فناوری، به تنهایی یا در ترکیب با کشت سلولی، با یک روش تشخیص مناسب، ممکن است به عنوان جایگزینی برای یک یا هر دو روش تکمیلی تشخیص مایکوپلاسما پس از تأیید اعتبار و موافقت مرجع ملی نظارتی مورد استفاده قرار گیرد.
الزامات سازمان جهانی بهداشت (WHO) برای استریلیتی در سال 1973 به تصویب رسید. بخش مربوط به آزمایش مایکوپلاسما در سال 1998 به دنبال پیشرفت های فنی در این زمینه اصلاح شد.
- مقالات بیشتر:
- تست اندوتوکسین چیست
- عملکرد اندوتوکسین
- اندوتوکسین و اگزوتوکسین چیست
- روش مستقیم برای آزمایش بار زیستی
شرکت نیکوفارمد تست استریلیتی را برای محصولات دارویی، رادیوداروها، دستگاه های پزشکی و آب ارائه می دهد. آزمایش استریلیتی در طول فرآیند اعتبار سنجی استریلیزاسیون مورد نیاز است. سه روش تست استریلیت عبارتند از فیلتراسیون غشایی، انتقال مستقیم (غوطهورسازی محصول) و شستشوی محصول.
FDA قانون نهایی آزمایش استریلیتی محصولات بیولوژیکی را صادر می کند که انعطاف پذیری بیشتری برای توسعه روش های تست استریلیتی ارائه می دهد. هدف از اصلاحات به شرح زیر است:
- ارتقاء بهبود و نوآوری در توسعه روش های تست استریلیتی
- به چالش های محصولات جدیدی که ممکن است در آینده به بازار معرفی شوند، رسیدگی کنید
- پتانسیل بهبود تست استریلیتی محصولات تایید شده فعلی
شرکت نیکوفارمد می تواند تمام این خدمات را علاوه بر تست سنتی استریلیتی ارائه دهد.
روش فیلتراسیون غشایی برای تست استریلیتی
تست استریلیتی فیلتراسیون غشایی روش انتخابی برای محصولات دارویی است. استفاده مناسب از این آزمایش برای دستگاه هایی است که حاوی مواد نگهدارنده و باکتریواستاتیک(یعنی مانع از تکثیر باکتری می شود ) و قارچ استاتیک(مانع از رشد قارچ می شود) به روش انتقال مستقیم هستند.در فیلتراسیون غشایی میکروارگانیسم ها روی سطح یک فیلتر که اندازه منافذ آن کمتر از میکرون است جمع می شوند. این فیلتر تقسیم بندی شده و به محیط کشت مناسب منتقل می شود. محیط کشت عبارتند از محیط تیوگلیکولات سیال (FTM) و محیط هضم کازئین سویا (SCDM) . FTM برای رشد میکروارگانیسم های بی هوازی و هوازی انتخاب می شود. SCDM برای رشد طیف گسترده ای از باکتری ها و قارچ های هوازی (به عنوان مثال، مخمرها) انتخاب می شود. زمان انکوباسیون 14 روز است.
تست استریلی انتقال مستقیم
این متد روش انتخابی برای دستگاه های پزشکی است زیرا دستگاه در طول دوره انکوباسیون در تماس مستقیم با محیط های کشت است. میکروارگانیسم های زنده ای که ممکن است پس از استریلیتی در محصول یا روی آن باقی بمانند، محیط ایده آلی برای رشد و تکثیر دارند. این امر به ویژه در مورد میکروارگانیسمهای آسیبدیده که آسیب ناشی از فرآیند استریلیتی باعث مرگ آنها نشده است، صادق است. همه میکروارگانیسم ها دارای مکانیسم های ترمیم بیولوژیکی هستند که می توانند از شرایط محیطی مساعد برای رشد استفاده کنند. روش انتقال مستقیم به نفع این میکروارگانیسم های آسیب دیده است. کل محصول باید در مایع آزمایش غوطه ور شود. با دستگاه های بزرگ، نواحی تماس بیمار باید غوطه ور شوند. نیکوفارمد درک می کند که به دلیل اندازه و شکل نمونه های آزمایشی، اصلاحات مناسب مورد نیاز است. این روش مستلزم آن است که محصول به ظروف جداگانه FTM و SCDM منتقل شود. محصول به صورت آسپتیک برش داده می شود یا به طور کامل به ظروف دارای محیط مناسب منتقل می شود. پس از انتقال، نمونه ها به مدت 14 روز انکوبه می شوند.
تست استریلیت فلاش محصول
تست استریلیت فلاش محصول برای محصولاتی که دارای لوله های توخالی هستند مانند مجموعه های انتقال خون و انفوزیون که در آن غوطه وری غیرعملی است و مسیر مایع به عنوان استریل برچسب گذاری شده است، اختصاص دارد. انجام این روش آسان است و نیاز به اصلاح محیط FTM برای دستگاه های لومن کوچک دارد. محصولات با سیال شسته شده و محلول شستشو با غشاء فیلتر شده و در FTM و SCDM قرار می گیرد.
محصولات دارویی فله / بیولوژیک و داروسازی
مواد دارویی (APIs) قبل از انتشار در فرآیندهای تولیدی، از نظر استریلیتی در هر USP 71 آزمایش می شوند. بیولوژیک های فله بر اساس 21 CFR 610.12 برای تست استریلی تست می شوند. این روش به یک محیط (FTM) نیاز دارد.
مناسب بودن و اعتبارسنجی
تست استریلیتی USP شامل دو سنجش واجد شرایط است که باید انجام شود. آنها عبارتند از "آزمون مناسب بودن" (تست ارتقای رشد) و تست اعتبار سنجی (آزمایش باکتریوستاز و قارچ).
تست تناسب برای تایید اینکه هر مقدار از محیط رشد مورد استفاده در روش تست استریلیتی از رشد کمتر از 100 میکروارگانیسم زنده پشتیبانی می کند استفاده می شود. اگر محیط کشت برای رشد ارگانیسم های شاخص مناسب نباشد، آنگاه آزمون با شکست مواجه می شود. ثانیاً، بخشی از هر محیط کشت به عنوان کنترل منفی و برای بررسی عدم آلودگی محیط در نظر گرفت شود. اگر مشخص شود که محیط غیراستریل است، آزمایش با شکست مواجه می شود.
آزمون اعتبارسنجی برای تعیین اینکه آیا نمونه آزمایشی از رشد میکروارگانیسم ها در محیط آزمایش جلوگیری می کند یا خیر استفاده می شود. استاز، از نظر میکروبیولوژیکی، به عنوان ناتوانی یک میکروارگانیسم در رشد و تکثیر در محیط های میکروبیولوژیکی تعریف می شود. محیط هایی که باکتریواستاتیک هستند لزوماً باکتری ها را از بین نمی برند. ممکن است به سادگی از رشد و تکثیر باکتری ها جلوگیری کند. تست اعتبار سنجی باید بر روی هر محصول قبل و/یا در طول آزمایش استریلیتی انجام شود. این آزمایش تعیین می کند که آیا مقدار محیط کشت برای محصول خاص معتبر هستند یا خیر. برخی از محصولات پزشکی حاوی ترکیبات باکتریواستاتیک و قارچ استاتیک هستند که ممکن است نیاز به روش های خاص و محیط های مخصوص برای آزمایش داشته باشند. این آزمایش مشابه تست مناسبی است که در بالا توضیح داده شد، با این حال، نمونه محصول همراه با میکروارگانیسم ها در محیط قرار می گیرد. رشد میکروبی در حضور نمونه های آزمایشی با گروه شاهد بدون نمونه آزمایش مقایسه می شود. اگر رشد میکروبی در ظروف نمونه و شاهد وجود داشته باشد، آزمایش معتبر است. تست های مناسب بودن، اعتبارسنجی و استریلیتی را می توان به طور همزمان انجام داد.
تفسیر نتایج تست استریلیتی
در طول دوره انکوباسیون، محیط کشت برای رشد مشاهده می شوند. محیط باید در برابر منبع نور شفاف باشد. مناطق کدر (ابری) در محیط ها نشان دهنده رشد میکروبی است. هنگامی که رشد تشخیص داده شد، آزمایش می شود تا تأیید شود که کدورت موجود به دلیل میکروارگانیسم ها است نه به دلیل تجزیه نمونه. گاهی اوقات نمونه ها به دلیل ریزش ذرات یا واکنش های شیمیایی با محیط تولید کدورت می کنند. هنگامی که یک ظرف مشکوک آزمایش شد، باید برای باقیمانده دوره انکوباسیون به انکوباتور بازگردانده شود. نمونه هایی که محیط را کدر می کنند در روز 14 آزمایش منتقل شده و به مدت چهار روز انکوبه می شوند. نمونه های رشد مثبت نیاز به پردازش بیشتری دارند.
منابع
- European Pharmacopoeia, Third Edition. Supplement 1998, Council of Europe, Strasbourg.
- PIC/S Annex 1 to the Guide to Good Manufacturing Practice for Medicinal Products - Manufacture of Sterile Medicinal Products. Document PH 1/97, (Rev. 3), 15 January 2002.
- PIC/S Recommendation on the Isolators used for Aseptic Processing and Sterility Testing, PI 014, 24 June 2002.
- United States Pharmacopeia (USP) 43<71> STERILITY TESTS.